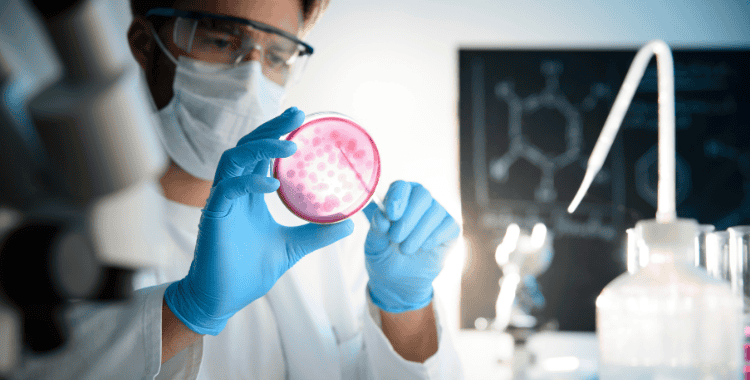

We at Janasnehi Diagnostic Center, believe that accurate diagnosis should be accessible to everyone. We provide highly accurate yet affordable Flu Panel PCR Testing in Bangalore, guided by an experienced team of microbiologists, pathologists, molecular diagnostics specialists, and trained laboratory technicians. With our advanced molecular reports doctors identify the exact cause of flu-like symptoms early and start the right treatment without delay. As our diagnostic center is centrally located in Bangalore, people from across the city can be easily reached by all types of transport, making it convenient. With the latest molecular testing technology, our state-of-the-art PCR laboratory ensures early and accurate detection of viral infections. For identifying the exact viral cause of cold, cough, fever, body pain, and respiratory symptoms, you need to go through the Flu Panel PCR Test. Each test is performed under strict quality-control standards using NABL-approved equipment, ensuring accurate results at an affordable cost.
What Does a Flu Panel PCR Test Detect?
To differentiate between viral infections, doctors prescribe a Flu Panel PCR Test. As it often show similar symptoms with other infections. By doing this test you can avoid unnecessary medications and reducing treatment costs. A standard Flu Panel PCR Test can detect:
- • Influenza A
- • Influenza B
- • RSV (Respiratory Syncytial Virus)
- • Adenovirus
- • Parainfluenza Virus
- • Other common respiratory viruses (as per panel selection)
When Should You Get a Flu Panel PCR Test?
To prevent complications and reduce overall medical expenses, you must go through early testing. You should consider a Flu Panel PCR Test if you have:
- • Cold, cough, or fever lasting more than 2–3 days
- • High fever with body pain, headache, or fatigue
- • Breathing difficulty, chest congestion, or wheezing
- • Flu-like symptoms in children, elderly, or high-risk individuals
- • Recurrent infections or seasonal flu outbreaks
- • A doctor’s advice before starting antiviral treatment
Why Choose Janasnehi Diagnostic Center?
Accuracy and affordability matter when choosing the right diagnostic center. Without compromising on quality our center stands as the best Diagnostic Center in Bangalore because:
- • We offer affordable Flu Panel PCR testing without compromising quality
- • Comprehensive diagnostics including CBC, HbA1c, thyroid tests, vitamin D, LFT, KFT, CT scans, MRI, and more
- • Advanced PCR technology for early and precise viral detection
- • Easy appointment booking and patient-friendly staff
- • Convenient access from Chamrajpet, KR Market, Avenue Road, and nearby areas
- • Quick and reliable reports, often available the same day or within 24 hours
- • Strict quality control and safety standards for every test
Frequently Asked Questions
Your Health Shouldn’t Be Expensive
The first step toward effective treatment is accurate diagnosis. At Janasnehi Diagnostic Center, we combine advanced PCR technology, expert medical oversight, and affordable pricing to ensure quality diagnostics for everyone.
If you are looking for an affordable diagnostic center for Flu Panel PCR testing in Bangalore, trust Janasnehi Diagnostic Center for accurate results, quick reports, and patient-friendly costs—because your health deserves timely and affordable care.